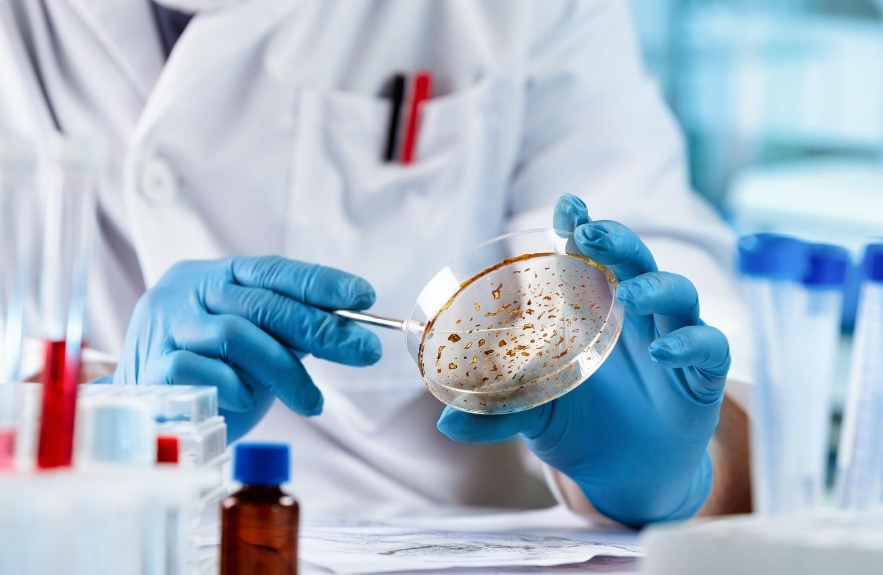

ТОП
ПОЛИТИКА
Президентът Румен Радев посети границата с Турция заради мигрантите
Президентът ген. Румен Радев посети ГКПП „Капитан Андреево“ и Елхово, където се запозна на място с предприетите мерки за...
Манолова внесе в парламента компенсации по 6 000 лв. на фирма с намален оборот и на самоосигуряващи се
ПГ „Изправи се БГ! Ние идваме!“ внесе законопроект за подкрепа с 300 млн. лв. на фирмите в условията на COVID-19. Той касае...
Увеличиха броят на децата в детските градини в община Благоевград
С решение на Общински съвет Благоевград бе увеличен броят на децата в детските градини на Община Благоевград На проведеното...
Кметът Илко Стоянов: Имаме практическо решение на проблема с безстопанствените кучета в Благоевград
Проблемите в Община Благоевград са много, търсим решение на всеки един от тях, каза на пресконференция кметът Илко Стоянов....
Общински съвет Благоевград прие предложение за увеличаване броя на децата в детските градини
Важни решения взеха общинските съветници на днешното извънредно заседание на Общински съвет Благоевград, което бе свикано от председателя Радослав...